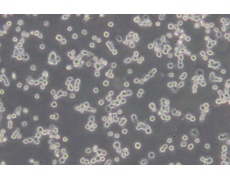
大鼠細(xì)胞系

基本信息
產(chǎn)品品牌 :通蔚生物
中文名稱 :大鼠肺泡巨噬細(xì)胞
細(xì)胞簡稱 :N R8383 [A gC 11x3A;N R8383.1]
細(xì)胞別稱 :N R-8383;NR 8383;N R8383.1;A gC 11x3A;Norm alR at,A ugust3,1983
細(xì)胞形態(tài) :巨噬細(xì)胞樣
生長特性 :半貼半懸
培養(yǎng)環(huán)境 :空氣,95% ;CO2,5% 37℃
凍存條件 :55% 基礎(chǔ)培養(yǎng)基+40% FBS+5% D M SO液氮
完全培養(yǎng)基 :Ham'sF-12K (PM 150910)+20% F B S(164210-50)+1% P /S(P B 180120)
傳代步驟
1、該細(xì)胞為半貼壁半懸浮細(xì)胞,懸浮細(xì)胞是活細(xì)胞,可用離心管收集細(xì)胞懸液后,于1200 rpm (250g左右)離心收集細(xì)胞。
2、部分貼壁不牢的細(xì)胞可直接吹起使之懸浮。
3、貼壁較牢固的細(xì)胞可用PBS潤洗后,在培養(yǎng)瓶中加入1~2毫升0.25% 胰蛋白酶溶液(含ED T A )置于 37℃培養(yǎng)箱中消化,待細(xì)胞變圓收縮后可用4~ 6 m L左右完全培養(yǎng)基進(jìn)行終止消化,輕輕吹散細(xì)胞后離心搜集細(xì)胞。
4、將懸浮的細(xì)胞和貼壁的細(xì)胞收集到一起混勻后按比例接種到新的培養(yǎng)瓶。
傳代比例(密度) :2×10^ 5-5×10^ 5cells/m L
換液頻次 :2~ 3次/周
細(xì)胞背景描述
N R 8383細(xì)胞來源于肺灌洗時的正常大鼠肺泡巨噬細(xì)胞,N R 8383細(xì)胞在G erbil肺細(xì)胞連續(xù)培養(yǎng)液存在下培養(yǎng)了8-9個月。隨后,N R 8383細(xì)胞不再需要外源生長因子。通過有限稀釋法,從單個細(xì)胞克隆并亞克隆N R 8383細(xì)胞,并3次用軟瓊脂亞克隆。N R 8383細(xì)胞表現(xiàn)出巨噬細(xì)胞的特性:吞噬酵母多糖和銅綠、非特異性脂酶活性、Fc受體、氧化降解;分泌IL-1、T N F beta和IL-6,可重復(fù)地響應(yīng)外源生長因子。N R 8383細(xì)胞響應(yīng)博萊霉素,分泌TG F beta前體。N R 8383細(xì)胞在博萊霉素刺激下,TG F betam RN A 表達(dá)也上升。N R8383細(xì)胞對內(nèi)毒素敏感,1-10n g/ml的LPS水平抑制增生達(dá)50% 。即使達(dá)到0.001m g/ml的水平,LPS抑制還是無毒且在后續(xù)過程中可逆的。N R 8383細(xì)胞提供了高響應(yīng)的肺泡巨噬細(xì)胞的均一來源,可以用于體外研究巨噬細(xì)胞相關(guān)活性,此細(xì)胞懸浮-貼壁混合生長。
組織來源 :肺;巨噬細(xì)胞;肺泡
細(xì)胞類型 :自發(fā)永生化細(xì)胞
生物安全等級 :1
受體表達(dá) :Fc
基因表達(dá) :tran sfo rming grow th factorbeta(TG F beta);in terleukin 1 (IL-1);in terleukin6 (IL-6)
細(xì)胞保藏中心 :ATCC;C R L-2192
收到常溫細(xì)胞后如何處理
細(xì)胞培養(yǎng)詳細(xì)操作步驟請參照通蔚生物細(xì)胞培養(yǎng)操作指南
1.收到常溫細(xì)胞后,及時拍照記錄有無漏液/瓶身破損現(xiàn)象。
2.用75%酒精擦拭細(xì)胞培養(yǎng)瓶表面,顯微鏡下觀察細(xì)胞狀態(tài)。先不要打開培養(yǎng)瓶蓋,將細(xì)
胞置于細(xì)胞培養(yǎng)箱內(nèi)靜置培養(yǎng)2-4小時,以便穩(wěn)定細(xì)胞狀態(tài)。
3.仔細(xì)閱讀細(xì)胞說明書,了解細(xì)胞相關(guān)信息,如貼壁特性(貼壁/懸浮)、細(xì)胞形態(tài)、所用
基礎(chǔ)培養(yǎng)基、血清比例、所需細(xì)胞因子、傳代比例、換液頻率等。
4.靜置完成后,取出細(xì)胞培養(yǎng)瓶,鏡檢、拍照,記錄細(xì)胞狀態(tài)(所拍照片 將作為后續(xù)服務(wù)
依據(jù));建議細(xì)胞傳代培養(yǎng)后,定期拍照、記錄細(xì)胞生長狀態(tài)。
5.若觀察到異?;蛘邔?xì)胞有疑問,請及時跟我們聯(lián)系;對于細(xì)胞培養(yǎng)操作及培養(yǎng)??筛覀兊募夹g(shù)支持交流。
 購物車
購物車 幫助
幫助
 021-54845833/15800441009
021-54845833/15800441009